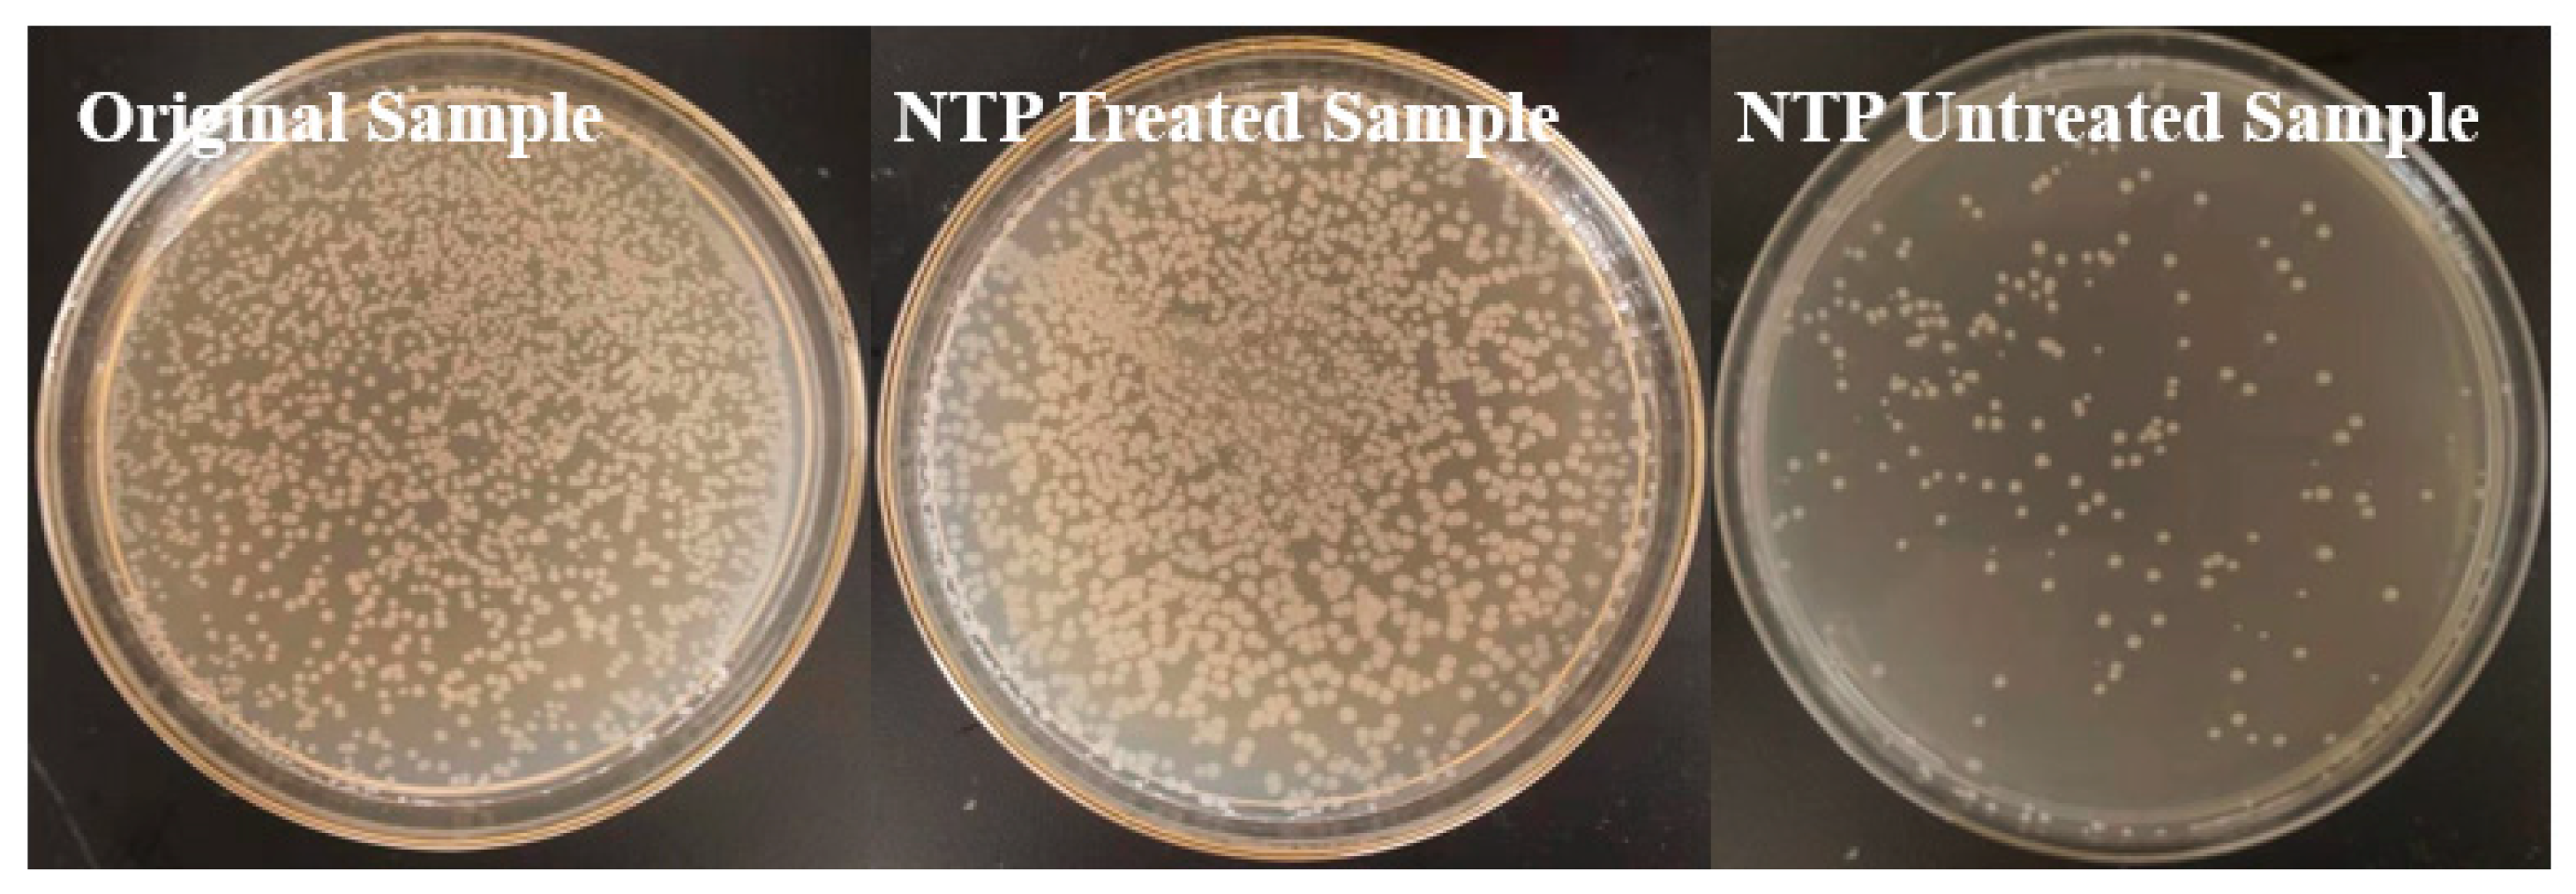
Catalysts 11 01169 g010 550

The Effect of Mass Transfer Rate-Time in Bubbles on Removal of Azoxystrobin in Water by Micro-Sized Jet Array Discharge
Abstract
:1. Introduction
2. Materials and Methods
2.1. Chemicals and Instruments
2.2. Plasma Reactor
2.3. Experimental Procedure
2.4. Analytical Methods
3. Results and Discussion
3.1. Effect of Voltage
3.2. Effect of Gas Flow Rate
3.3. Effect of Initial Solution Temperature
3.4. Removal Pathway Analysis
3.5. Toxicity Measurements
4. Conclusions
Supplementary Materials
Author Contributions
Funding
Conflicts of Interest
References
- Cooper, J.; Dobson, H. The benefits of pesticides to mankind and the environment. Crop Prot. 2007, 26, 1337–1348. [Google Scholar] [CrossRef]
- Pretty, J. Intensification for redesigned and sustainable agricultural systems. Science 2018, 362. [Google Scholar] [CrossRef] [PubMed] [Green Version]
- Huisman, J.; Codd, G.A.; Paerl, H.W.; Ibelings, B.W.; Verspagen, J.M.; Visser, P.M. Cyanobacterial blooms. Nat. Rev. Microbiol. 2018, 16, 471–483. [Google Scholar] [CrossRef] [PubMed]
- Lu, T.; Zhang, Q.; Lavoie, M.; Zhu, Y.; Ye, Y.; Yang, J.; Paerl, H.W.; Qian, H.; Zhu, Y.G. The fungicide azoxystrobin promotes freshwater cyanobacterial dominance through altering competition. Microbiome 2019, 7, 128. [Google Scholar] [CrossRef] [Green Version]
- Rodrigues, E.T.; Lopes, I.; Pardal, M.A. Occurrence, fate and effects of azoxystrobin in aquatic ecosystems: A review. Environ. Int. 2013, 53, 18–28. [Google Scholar] [CrossRef] [PubMed]
- The Japan Food Chemical Research Foundation. Maximum Residue Limits (MRLs) List of Agricultural Chemicals in Foods [EB/OL]. 2020. Available online: http://db.ffcr.or.jp/front/pesticide_detail?id=3500 (accessed on 3 February 2021).
- Xu, Y.; Li, B.; Hou, K.; Du, Z.; Allen, S.C.; Zhu, L.; Li, W.; Zhu, L.; Wang, J.; Wang, J. Ecotoxicity evaluation of azoxystrobin on Eisenia fetida in different soils. Environ. Res. 2021, 194, 110705. [Google Scholar] [CrossRef]
- Cao, F.; Zhu, L.; Li, H.; Yu, S.; Wang, C.; Qiu, L. Reproductive toxicity of azoxystrobin to adult zebrafish (Danio rerio). Environ. Pollut. 2016, 219, 1109–1121. [Google Scholar] [CrossRef]
- Vieira, R.S.; Venâncio, C.A.; Félix, L.M. Embryonic zebrafish response to a commercial formulation of azoxystrobin at environmental concentrations. Ecotoxicol. Environ. Saf. 2021, 211, 111920. [Google Scholar] [CrossRef]
- Franke, C.; Studinger, G.; Berger, G.; Böhling, S.; Bruckmann, U.; Cohors-Fresenborg, D.; Jöhncke, U. The assessment of bioaccumulation. Chemosphere 1994, 29, 1501–1514. [Google Scholar] [CrossRef]
- Xu, C.; Lin, X.; Yin, S.; Zhao, L.; Liu, Y.; Liu, K.; Li, F.; Yang, F.; Liu, W. Enantioselectivity in biotransformation and bioaccumulation processes of typical chiral contaminants. Environ. Pollut. 2018, 243, 1274–1286. [Google Scholar] [CrossRef]
- Posch, T.; Köster, O.; Salcher, M.; Pernthaler, J. Harmful filamentous cyanobacteria favoured by reduced water turnover with lake warming. Nat. Clim. Chang. 2012, 2, 809–813. [Google Scholar] [CrossRef] [Green Version]
- Nawrocki, J.; Kasprzyk-Hordern, B. The efficiency and mechanisms of catalytic ozonation. Appl. Catal. B Environ. 2010, 99, 27–42. [Google Scholar] [CrossRef]
- Rodriguez-Peña, M.; Barrios, J.; Becerril-Bravo, E.; Rodrigo, M.; Barrera-Díaz, C. Degradation of endosulfan by a coupled treatments in a batch reactor with three electrodes. Fuel 2020, 281, 118741. [Google Scholar] [CrossRef]
- Yang, L.; Liya, E.Y.; Ray, M.B. Degradation of paracetamol in aqueous solutions by TiO2 photocatalysis. Water Res. 2008, 42, 3480–3488. [Google Scholar] [CrossRef] [PubMed]
- Heo, I.; Kim, M.K.; Sung, S.; Nam, I.-S.; Cho, B.K.; Olson, K.L.; Li, W. Combination of Photocatalysis and HC/SCR for Improved Activity and Durability of DeNOx Catalysts. Environ. Sci. Technol. 2013, 47, 3657–3664. [Google Scholar] [CrossRef]
- Frontistis, Z.; Daskalaki, V.M.; Katsaounis, A.; Poulios, I.; Mantzavinos, D. Electrochemical enhancement of solar photocatalysis: Degradation of endocrine disruptor bisphenol-A on Ti/TiO2 films. Water Res. 2011, 45, 2996–3004. [Google Scholar] [CrossRef] [PubMed]
- Rodríguez-Peña, M.; Pérez, J.A.B.; Llanos, J.; Sáez, C.; Rodrigo, M.A.; Barrera-Díaz, C.E. New insights about the electrochemical production of ozone. Curr. Opin. Electrochem. 2021, 27, 100697. [Google Scholar] [CrossRef]
- Zong, Z.; Zhou, R.; Liu, D.; Song, Y.; Niu, J. Treatment of omethoate on edible wolfberry by atmospheric pressure air surface dielectric barrier discharge. Plasma Process. Polym. 2016, 13, 402–409. [Google Scholar] [CrossRef]
- Magureanu, M.; Mandache, N.B.; Parvulescu, V.I. Degradation of pharmaceutical compounds in water by non-thermal plasma treatment. Water Res. 2015, 81, 124–136. [Google Scholar] [CrossRef] [PubMed]
- Chen, C.; Liu, D.X.; Liu, Z.C.; Yang, A.J.; Chen, H.L.; Shama, G.; Kong, M.G. A model of plasma-biofilm and plasma-tissue interactions at ambient pressure. Plasma Chem. Plasma Process. 2014, 34, 403–441. [Google Scholar] [CrossRef]
- Bruggeman, P.; Leys, C. Non-thermal plasmas in and in contact with liquids. J. Phys. D Appl. Phys. 2009, 42, 053001. [Google Scholar] [CrossRef]
- Michael, G.K.; Liu, D.X. Researches on the Interaction Between Gas Plasmas and Aqueous Solutions: Significance, Challenges and New Progresses. High Volt. Eng. 2014, 40, 2956–2965. [Google Scholar]
- Graves, D.B. The emerging role of reactive oxygen and nitrogen species in redox biology and some implications for plasma applications to medicine and biology. J. Phys. D Appl. Phys. 2012, 45, 263001. [Google Scholar] [CrossRef]
- Malik, M.A.; Chaffar, A.; Malik, S.A. Water purification by electrical discharges. Plasma Sources Sci. Technol. 2001, 10, 82–91. [Google Scholar] [CrossRef]
- Zhou, R.W.; Zhou, R.S.; Wang, P.Y.; Luang, B.Y.; Zhang, X.H.; Fang, Z.; Xian, Y.B.; Lu, X.P.; Ostrikov, K.K.; Bazaka, K. Microplasma Bubbles: Reactive Vehicles for Biofilm Dispersal. ACS Appl. Mater. Interfaces 2019, 11, 20660–20669. [Google Scholar] [CrossRef]
- Zhang, X.H.; Zhou, R.W.; Bazaka, K.; Liu, Y.; Zhou, R.S.; Chen, G.L.; Chen, Z.; Liu, Q.H.; Yang, S.Z.; Ostrikov, K. Quantification of plasma produced OH radical density for water sterilization. Plasma Process. Polym. 2018, 15, 1700241. [Google Scholar] [CrossRef]
- Liu, Y.; Zhang, H.; Sun, J.; Liu, J.; Shen, X.; Zhan, J.; Zhang, A.; Ognier, S.; Cavadias, S.; Li, P. Degradation of aniline in aqueous solution using non-thermal plasma generated in microbubbles. Chem. Eng. J. 2018, 345, 679–687. [Google Scholar] [CrossRef]
- Chen, B.; Zhu, C.; Fei, J.; Jiang, Y.; Yin, C.; Su, W.; He, X.; Li, Y.; Chen, Q.; Ren, Q.; et al. Reaction kinetics of phenols and p-nitrophenols in flowing aerated aqueous solutions generated by a discharge plasma jet. J. Hazard. Mater. 2019, 363, 55–63. [Google Scholar] [CrossRef]
- Balba, H. Review of strobilurin fungicide chemicals. J Environ. Sci Health B 2007, 42, 441–451. [Google Scholar] [CrossRef]
- Toor, H.L.; Marchello, J.M. Film-penetration model for mass and heat transfer. AIChE J. 1958, 4, 97–101. [Google Scholar] [CrossRef]
- Wang, C.; Xu, Z.; Lai, C.; Sun, X. Beyond the standard two-film theory: Computational fluid dynamics simulations for carbon dioxide capture in a wetted wall column. Chem. Eng. Sci. 2018, 184, 103–110. [Google Scholar] [CrossRef]
- Conrads, H.; Schmidt, M. Plasma generation and plasma sources. Plasma Sources Sci. Technol. 2000, 9, 441–454. [Google Scholar] [CrossRef] [Green Version]
- Kukushkin, V.Y.; Pombeiro, A.J. Additions to metal-activated organonitriles. Chem. Rev. 2002, 102, 1771–1802. [Google Scholar] [CrossRef]
- Radzicka, A.; Wolfenden, R. Rates of Uncatalyzed Peptide Bond Hydrolysis in Neutral Solution and the Transition State Affinities of Proteases. J. Am. Chem. Soc. 1996, 118, 6105–6109. [Google Scholar] [CrossRef]
- Yoshino, Y.; Hayashi, Y.; Iwahama, T.; Sakaguchi, A.S.; Ishii, Y. Catalytic oxidation of alkylbenzenes with molecular oxygen under normal pressure and temperature by N-hydroxyphthalimide combined with Co(OAc)2. J. Org. Chem. 1997, 62, 6810–6813. [Google Scholar] [CrossRef]
- Yabuta, T.; Hayashi, M.; Matsubara, R. Photocatalytic Reductive C–O Bond Cleavage of Alkyl Aryl Ethers by Using Carbazole Catalysts with Cesium Carbonate. J. Org. Chem. 2021, 86, 2545–2555. [Google Scholar] [CrossRef] [PubMed]
- Cornella, J.; Zarate, C.; Martin, R. Metal-catalyzed activation of ethers via C-O bond cleavage: A new strategy for molecular diversity. Chem. Soc. Rev. 2014, 43, 8081–8097. [Google Scholar] [CrossRef] [PubMed]
- Smadja, W. Electrophilic addition to allenic derivatives: Selectivity, regio- and stereochemistry and mechanisms. Chem. Rev. 1983, 83, 263–320. [Google Scholar] [CrossRef]

| Input Voltage (kV) | Power (W) | Yield (g/(kW·h)) | Pseudo First-Order Kinetic Constant | Removal Efficiency | |
|---|---|---|---|---|---|
| k (min−1) | R2 | ||||
| 6 | 1.19 | 1.17 | 0.16 | 0.883 | 86.9% |
| 8 | 2.14 | 0.73 | 0.30 | 0.964 | 98.1% |
| 10 | 12.62 | 0.12 | 0.37 | 0.937 | 98.7% |
| Gas Flow Rate | Bubble Number per Capillary per Second (N/s) | Number of Discharges in a Single Bubble (Theoretical Value) |
|---|---|---|
| 0.7 SLM | 200.4 | 29.9 |
| 1.5 SLM | 429.5 | 14.0 |
| 2.0 SLM | 560.7 | 10.7 |
| 3.5 SLM | 1001.7 | 6.0 |
| 5.0 SLM | 1401.9 | 4.2 |
Publisher’s Note: MDPI stays neutral with regard to jurisdictional claims in published maps and institutional affiliations. |
© 2021 by the authors. Licensee MDPI, Basel, Switzerland. This article is an open access article distributed under the terms and conditions of the Creative Commons Attribution (CC BY) license (https://creativecommons.org/licenses/by/4.0/).
Share and Cite
Chen, F.; Yang, D.; Yu, F.; Kun, Y.; Song, Y. The Effect of Mass Transfer Rate-Time in Bubbles on Removal of Azoxystrobin in Water by Micro-Sized Jet Array Discharge. Catalysts 2021, 11, 1169. https://doi.org/10.3390/catal11101169
Chen F, Yang D, Yu F, Kun Y, Song Y. The Effect of Mass Transfer Rate-Time in Bubbles on Removal of Azoxystrobin in Water by Micro-Sized Jet Array Discharge. Catalysts. 2021; 11(10):1169. https://doi.org/10.3390/catal11101169
Chicago/Turabian StyleChen, Feng, Dezheng Yang, Feng Yu, Yang Kun, and Ying Song. 2021. "The Effect of Mass Transfer Rate-Time in Bubbles on Removal of Azoxystrobin in Water by Micro-Sized Jet Array Discharge" Catalysts 11, no. 10: 1169. https://doi.org/10.3390/catal11101169
APA StyleChen, F., Yang, D., Yu, F., Kun, Y., & Song, Y. (2021). The Effect of Mass Transfer Rate-Time in Bubbles on Removal of Azoxystrobin in Water by Micro-Sized Jet Array Discharge. Catalysts, 11(10), 1169. https://doi.org/10.3390/catal11101169

